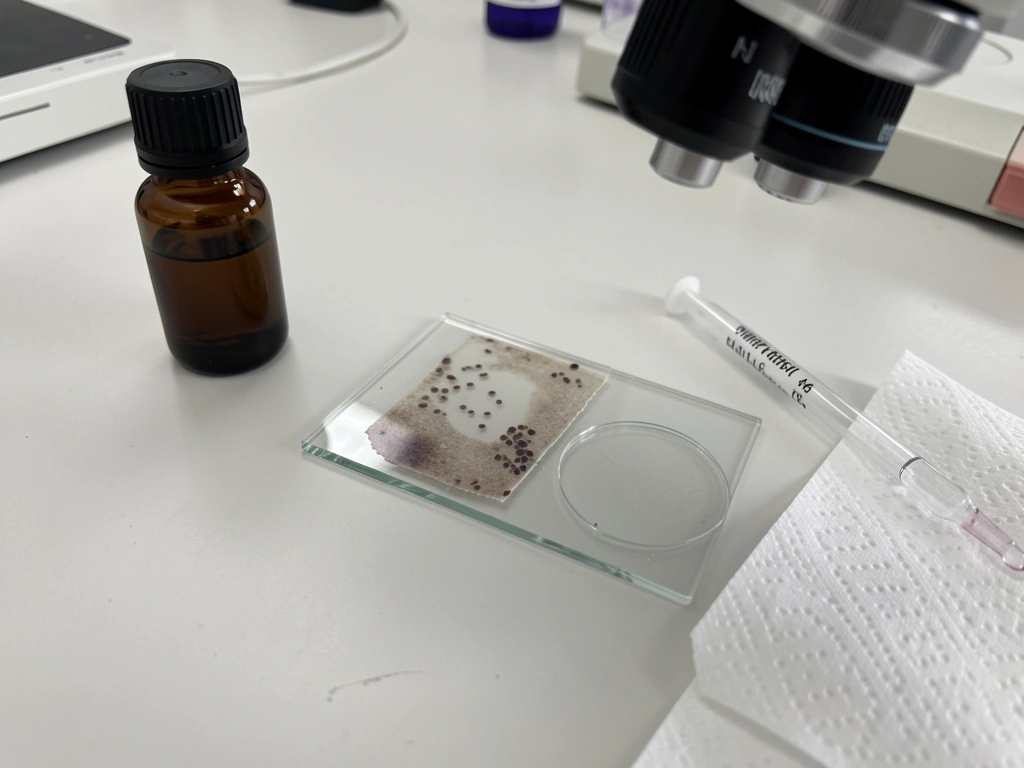
Prepared microscope smear materials laid out for confirming nucleated avian RBCs with staining.

Bird red blood cells have a nucleus because birds never evolved the enucleation step that mammals use. That's the short answer. The longer answer is that retaining the nucleus is actually a deliberate evolutionary tradeoff, one that costs birds something in oxygen-carrying efficiency but gives them something back in cellular flexibility. If you've been staring at a biology textbook wondering why your professor said "only mammals lose the nucleus," here's the full picture.
Why Do Bird Red Blood Cells Have Nucleus? Key Reasons
Red blood cell basics: what a nucleus actually does

A nucleus is basically the cell's command center. It holds the DNA and coordinates protein production. For most cell types, having a nucleus is non-negotiable, because the cell needs to copy itself, respond to signals, and synthesize proteins. Red blood cells are one of the weird exceptions, at least in mammals.
In mammals, the red blood cell (called an erythrocyte) goes through several developmental stages inside the red bone marrow. One of those stages is called the normoblast, which is a nucleated precursor cell that still looks like a "real" cell with a full nucleus. Then, just before the cell is released into the bloodstream, it ejects its nucleus and becomes a reticulocyte, and eventually a mature erythrocyte. No nucleus, no DNA, no protein synthesis. The mature mammalian RBC is essentially a biconcave bag of hemoglobin designed to do one thing: carry oxygen.
The payoff for losing the nucleus is space. Without that big nucleus taking up room, the mammalian RBC can pack in more hemoglobin, the iron-containing protein that actually binds and transports oxygen. More hemoglobin per cell means more oxygen-carrying capacity. It's a pretty elegant design, and it's probably why mammals can sustain high activity levels with relatively compact blood cells.
Bird vs mammal RBCs: the structural differences you'd actually see

If you put a drop of bird blood and a drop of human blood on slides, stained them, and looked through a microscope, you'd notice the difference immediately. Bird RBCs are oval-shaped and noticeably larger than human RBCs. And right in the middle of each bird RBC, you'd see a dark-staining oval blob: the nucleus. Human RBCs, by contrast, look like little pale discs with a lighter center and no nucleus at all.
| Feature | Mammalian RBC | Avian RBC |
|---|---|---|
| Shape | Biconcave disc (round) | Oval / elliptical |
| Nucleus present | No (anucleate in mature form) | Yes (nucleated throughout life) |
| Ability to synthesize proteins | No | Yes (limited) |
| Ability to divide | No | No (non-dividing in circulation) |
| Relative hemoglobin density | Higher (more room without nucleus) | Lower (nucleus occupies space) |
| Cell lifespan | ~120 days (humans) | ~28–45 days (varies by species) |
| Size | Smaller (~6–8 µm diameter) | Larger (~12–14 µm long axis) |
The oval shape of avian RBCs is worth noting on its own. It's not just cosmetic. Oval cells with a nucleus tend to be slightly less flexible than the biconcave mammalian RBC, which can squeeze through capillaries smaller than the cell itself. Bird capillaries are generally sized to accommodate their oval cells, so this works out fine for them.
Why birds kept the nucleus: evolution and tradeoffs

This is the part I kept getting wrong when I first learned it. I assumed that losing the nucleus was obviously "better" and that birds just hadn't gotten around to it evolutionarily. But that's not quite right. Birds and mammals both evolved from reptilian ancestors, and most non-mammalian vertebrates, including reptiles, amphibians, and fish, have nucleated red blood cells. Mammals are actually the unusual group here. The enucleation of RBCs appears to be a mammal-specific adaptation, not a universal vertebrate strategy.
So why did birds stick with nucleated RBCs? A few reasons are well-supported, and a few are still debated among researchers.
The case for keeping the nucleus

- Metabolic flexibility: Because avian RBCs retain their nucleus and can still carry out limited protein biosynthesis, they can respond to physiological changes in ways mammalian RBCs cannot. This may help birds adapt their RBCs during stress, altitude changes, or high-demand flight.
- Gene expression on the fly: A nucleated cell can still transcribe RNA and adjust its protein production. This gives bird RBCs a small but real ability to respond to their environment that mammalian RBCs simply don't have.
- Evolutionary inertia: Birds' ancestors already had nucleated RBCs. There's no strong evidence that natural selection ever favored losing the nucleus in the avian lineage, especially since birds found other ways to meet their high oxygen demands (more on that below).
- Cryopreservation and research value: This is a practical bonus, not an evolutionary driver, but avian RBCs' ability to synthesize proteins makes them more useful in certain lab research contexts, including cryopreservation studies, than mammalian RBCs.
The cost of keeping the nucleus
The nucleus takes up physical space inside the cell, which means there's less room for hemoglobin. Fewer hemoglobin molecules per cell means each individual bird RBC carries less oxygen than a mammalian RBC of equivalent size. Birds compensate for this in several ways: higher heart rates, more efficient lungs (the avian lung with its parabronchi and air sacs is a remarkable piece of engineering), and generally maintaining higher red blood cell counts per unit of blood volume. The system works, it's just built differently.
Bird RBCs also have a shorter lifespan than human RBCs. A human red blood cell lives about 120 days. Avian RBC lifespans vary by species but are generally estimated in the range of 28 to 45 days. That faster turnover means the bird's bone marrow is working harder to replace cells, which is a metabolic cost. Whether the shorter lifespan is directly related to the nucleated state or to other factors like bird metabolic rate is still an active area of investigation.
How nucleated RBCs affect oxygen delivery in birds
You might expect that having less efficient RBCs would limit birds, especially species like bar-headed geese that migrate over the Himalayas at altitudes where oxygen is brutally thin. But birds have solved this problem at multiple levels of their physiology, not just at the cellular level.
First, avian hemoglobin itself. Some bird species, particularly high-altitude migrants, have hemoglobin variants with a higher oxygen affinity, meaning they bind oxygen more readily even in low-oxygen environments. This is an adaptation at the molecular level, separate from the RBC structure question.
Second, the avian respiratory system is fundamentally more efficient than the mammalian system. Birds breathe in a unidirectional flow through their lungs using a system of air sacs, so fresh air is always moving over the gas exchange surfaces. Mammals use a tidal (in-and-out) system, which means there's always some stale air mixing with fresh air. The bird lung extracts oxygen more efficiently per breath, which partially offsets the per-cell hemoglobin disadvantage.
Third, birds typically have a higher red blood cell count per volume of blood than many mammals do, which compensates for the lower per-cell capacity. The system as a whole delivers plenty of oxygen for flight, which is one of the most aerobically demanding activities in the animal kingdom.
How to confirm this yourself: what to look for
If you want to verify this beyond taking my word for it, here's a practical roadmap depending on your situation.
On a microscope slide
The most direct confirmation is a Giemsa-stained or Wright's-stained blood smear. If you have access to a microscope and a prepared avian blood smear (commonly available in university biology lab kits or from biological supply companies), you'll see the oval RBCs with a clearly visible, darkly stained oval nucleus in the center of each cell. Compare this to a human blood smear on the same slide, and the structural difference is obvious. The bird cells are bigger, oval, and each one has that central dark spot. The human cells are smaller, round, and the center is just a pale area with no nucleus.
For staining, Wright's stain colors the nucleus dark purple-blue and the cytoplasm pinkish-orange. This is the standard approach used in veterinary and comparative hematology labs. If you're a student preparing for an exam or lab practical, this is exactly what your instructor wants you to describe.
In textbooks and reputable sources
For written confirmation, comparative vertebrate physiology textbooks are your best bet. Look for chapters on hematology or blood physiology in texts covering avian biology. Veterinary hematology references (especially those covering exotic animals and birds) describe avian RBC morphology in detail. PubMed-indexed literature on avian erythrocytes or cryopreservation of avian blood cells will also confirm that these cells retain their nucleus and retain limited protein biosynthesis capability, unlike their mammalian counterparts.
Exceptions and edge cases to know about
Here's a gotcha that trips people up: mammalian blood is not always completely free of nucleated red blood cells. In certain disease states (hemolytic anemia, some cancers, severe infections), immature nucleated RBC precursors called normoblasts can be pushed out of the bone marrow into circulation before they complete enucleation. Seeing nucleated RBCs in a mammalian blood smear is actually a clinical red flag. In birds, it's completely normal. Don't confuse the two.
Another edge case: within birds, there are some reports of variation in RBC nuclear size and activity level depending on species, age, and physiological state. A bird under severe stress or during heavy molting may show different RBC characteristics than a bird at rest. Scientists still debate some of the finer details of how much functional variation exists between species. The core fact (avian RBCs are nucleated) is solid, but the nuances of how much that nucleus does are still being studied.
Common questions and misconceptions about bird RBCs
"Does having a nucleus mean bird RBCs aren't 'real' red blood cells?"
P|No. "Red blood cell" or "erythrocyte" simply refers to the cell type responsible for oxygen transport in blood. The anucleate state of mammalian RBCs is a derived characteristic unique to mammals, not a defining feature of erythrocytes across all vertebrates. Nucleated erythrocytes are the ancestral condition. Calling bird RBCs "not real" red blood cells would be like saying fish gills aren't real respiratory organs because they're not lungs.
"Do bird RBCs divide?"
Having a nucleus doesn't automatically mean the cell divides. Mature avian RBCs circulating in the blood do not actively divide. New RBCs are still produced in the bone marrow, just like in mammals. The nucleus in a circulating avian RBC is metabolically active to some degree but is not directing cell division in the bloodstream.
"Is bird blood a different color because of the nucleus?"
No. Bird blood is red for the same reason mammalian blood is red: hemoglobin changes color depending on whether it's carrying oxygen (bright red when oxygenated, darker red when deoxygenated). The nucleus doesn't change the color of the blood. If you've seen questions about whether bird blood might look different (you might have come across the related question of whether bird blood could appear purple under certain conditions), that's about oxygenation state and lighting, not RBC structure. The red color comes from the hemoglobin, full stop.
"Why do mammals lose the nucleus if birds do fine without losing it?"
This is the genuinely interesting evolutionary question, and honest answer: scientists don't have a single definitive explanation. The leading hypothesis is that enucleation allowed mammals to pack more hemoglobin into each cell, which supports the high-metabolic-rate lifestyle of endothermic (warm-blooded) mammals. But birds are also endothermic and active, and they evolved a different solution set (better lungs, higher heart rates, different hemoglobin chemistry). Evolution doesn't always find the same solution to the same problem. Both systems work; they're just different engineering approaches.
"Can I see the bird RBC nucleus without a microscope?"
No. RBCs, nucleated or not, are microscopic. You need a light microscope and a properly stained smear to see the nucleus. A good starting magnification is 400x, and oil-immersion at 1000x gives you a very clear view of the cellular detail. This is standard procedure in any comparative physiology or veterinary hematology lab course.
What to do with this information
If you're studying for a biology or physiology exam, the key facts to lock in are: avian RBCs are nucleated and oval-shaped, mammalian RBCs are anucleate and biconcave, the nucleated state allows limited protein biosynthesis in bird RBCs, and this comes at the cost of lower per-cell hemoglobin density, which birds compensate for with respiratory and cardiovascular adaptations.
If you're trying to explain this to someone else, the clearest analogy is storage space: mammalian RBCs cleared out all the furniture (nucleus included) to make room for as much cargo (hemoglobin) as possible. Birds kept some furniture in and compensated by building a better delivery system overall.
If you want to go deeper, avian physiology is genuinely fascinating and connects to a lot of other surprising bird biology. The way birds manage gas exchange, color vision, and sensory systems is full of similarly counterintuitive details that reward a closer look.
FAQ
Do bird red blood cells still need a nucleus to make proteins, or is the nucleus just leftover structure?
Bird RBCs keep the nucleus and can retain limited molecular activity, meaning the cell has more capacity for gene-dependent protein synthesis than a mature mammalian RBC. The key point is that circulating avian RBCs do not behave like dividing cells, they mainly trade off some oxygen capacity for extra cellular flexibility compared with mammals.
If birds compensate with higher heart rates and more RBCs, why not always evolve to enucleate like mammals?
Enucleation is beneficial mainly when you can maximize hemoglobin packing and accept the loss of that nuclear-related cellular flexibility. Birds already “pay” the nucleus cost but offset it with an efficient respiratory system and high oxygen delivery at the whole-organism level, so the net evolutionary pressure to remove nuclei is weaker or uneven across lineages.
Are bird RBCs always oval, and is the nucleus always easy to see?
Most bird species show oval RBCs with a visible central nucleus on properly stained smears, but size, staining intensity, and nuclear prominence can vary with species, age, and physiological state (for example, during stress or molting). If the smear is too thick, under-stained, or delayed after collection, the nucleus can look faint.
Do nucleated RBCs in birds mean their RBCs actively divide in the bloodstream?
No. The nucleus in a circulating avian RBC does not imply ongoing cell division. RBCs are produced in the bone marrow, then enter circulation as mature cells, so the nucleus is not acting as a “division switch” while the cells are in blood.
Can bird RBCs carry less oxygen than mammalian RBCs because of less hemoglobin per cell?
Per cell, bird RBCs typically have less hemoglobin packing because the nucleus occupies space. But oxygen delivery depends on more than per-cell content, birds compensate with higher RBC counts and very effective lung ventilation patterns, so total oxygen uptake and delivery can still meet high demands like sustained flight.
Why would someone see nucleated red cells in mammals, and how can you tell it apart from normal bird blood?
In mammals, nucleated RBCs usually appear only when immature precursors are forced into circulation, often seen in hemolytic anemia, severe infection, or certain cancers. A mammal’s normal smear should show anucleate discs, so any nucleated RBCs are typically treated as a diagnostic warning sign rather than a species trait.
Does the nucleus affect the shape or flexibility of bird RBCs in a way that matters?
Yes, keeping a nucleus and using an oval shape generally makes cells less flexible than the classic mammalian biconcave discs. Birds solve this partly by having capillary and circulatory conditions suited to their RBC morphology, but extreme crowding or disease can still affect microcirculation efficiency.
If I change staining type or magnification, will the nucleus in bird RBCs look the same?
The nucleus should remain identifiable with standard Romanowsky-type stains like Wright or Giemsa, but color intensity and contrast can change with stain thickness, pH, and time. For reliable comparison, use the same staining protocol and slide preparation quality, otherwise a nucleus can be missed or over-interpreted.
Can Bird See Color? How Bird Vision Compares to Humans
Yes, birds can see color and UV, with different spectral sensitivity than humans, used for food, mates, and predators.

